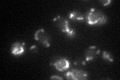
YMR241W

View description
Mitochondrial DNA-binding protein, component of the mitochondrial nucleoid structure, involved in mtDNA replication and segregation of mitochondrial genomes; member of the mitochondrial carrier protein family
Localization:
Intensity:
Fold change:
Significance:
-
C’ GFP library in SD

mitochondria148.44 -
N' NOP1pr-GFP in SD

mitochondria158.165 -
N' TEF2pr-mCherry in SD

mitochondria32.5763 -
N' NATIVEpr-GFP in SD

mitochondria61.3526 -
N' TEF2pr-VC and Cyto-VN in SD

mitochondria26.047 -
C’ GFP library in SD+DTT

mitochondria109.250.73No -
C’ GFP library in SD+H2O2

mitochondria133.410.89No -
C’ GFP library in Starvation Media
mitochondria67.870.45Yes -
C’ GFP library on the background of Pup2-DaMP

N/A -
C’ GFP library on the background of CCT mutant

N/A0N/AYes
